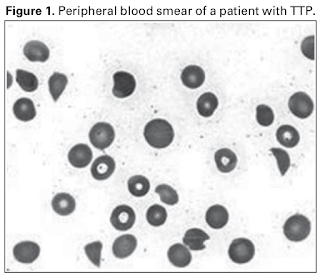

(J Bras Nefrol 2010;32(3):298-308)
・ICSH(International Council for Standardization in Hematology)では破砕赤血球≥1%をTMA診断の基準としている
・末梢血ギムザ染色で100倍視野でみると, RBCは1視野あたり100個程度.
10視野(1000RBC)で評価し, その平均値を求める.
(Int. Jnl. Lab. Hem. 2013, 35, 542–547)
破砕赤血球はどのような疾患で認めるか?
単一施設において6年間で行なった末梢血目視検査を評価
・患者はHb≤10g/dLを満たす群. 末梢血目視は282例.
・破砕赤血球はTMA以外にも血液腫瘍や悪性腫瘍, 敗血症, 慢性腎疾患など様々な病態で認められる.
・特にTMAで多いわけでもない.
(Int. Jnl. Lab. Hem. 2013, 35, 542–547)
末梢血で破砕赤血球を評価した146例を前向きに評価
・TMA以外にも敗血症や出産, 血液腫瘍などで認めるが, TMAでは最も割合が多い.
・ただし機械計算では少なく計算される(1%を超える場合)
・1%程度ならば様々な疾患であるため, TMAの診断のためには2%以上を有意と捉えるべきか
DICにおける破砕赤血球
DIC患者35例の末梢血を評価
・破砕赤血球を認めたのは30例
<0.5%が20例, 0.5-1%が6例, ≥1%が4例
平均0.33±0.38%, 中央値0.1%[0-1.4]
・Control群では0.21±0.25%, 中央値0.1%[0-0.4]と両者で有意差認められず
・DICでは破砕赤血球は認められるがその量は少ない.
82例のICU患者+DIC症例における解析では
・破砕赤血球のDICに対する感度は23%, 特異度73%
・LR+ 0.85, LR- 1.05とほぼ意味なし
(Crit Care Med 2000; 28:1777–1780)
------------------------
破砕赤血球はTMA以外にも様々な病態で認められる.
1%前後までは色々ありえるが, 2%を超えるのはTMAの可能性を考える.
確認は機械カウントではなく, 必ず目視で.
破砕赤血球はTMA以外にも様々な病態で認められる.
1%前後までは色々ありえるが, 2%を超えるのはTMAの可能性を考える.
確認は機械カウントではなく, 必ず目視で.